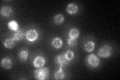
YKL068W
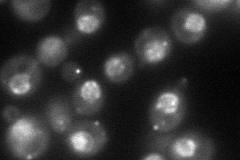
YKL068W
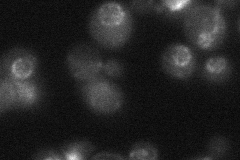
YKL068W
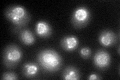
YKL068W

View description
Subunit of the nuclear pore complex (NPC) that is localized to both sides of the pore; contains a repetitive GLFG motif that interacts with mRNA export factor Mex67p and with karyopherin Kap95p; homologous to Nup116p
Localization:
Intensity:
Fold change:
Significance:
-
C’ GFP library in SD
nuclear periphery41.86 -
N' NOP1pr-GFP in SD
punctate,nuclear periphery87.5262 -
N' TEF2pr-mCherry in SD

punctate0 -
N' NATIVEpr-GFP in SD
punctate,nuclear periphery20.8714 -
N' TEF2pr-VC and Cyto-VN in SD

#N/A0 -
C’ GFP library in SD+DTT
nuclear periphery33.130.79No -
C’ GFP library in SD+H2O2

nuclear periphery34.420.82No -
C’ GFP library in Starvation Media

nuclear periphery46.721.11No -
C’ GFP library on the background of Pup2-DaMP

N/A -
C’ GFP library on the background of CCT mutant

N/A0N/AYes
